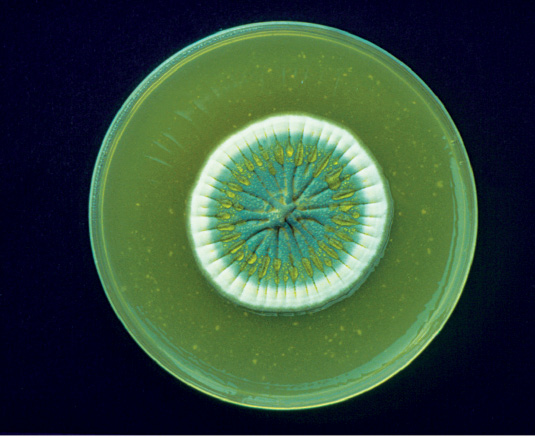
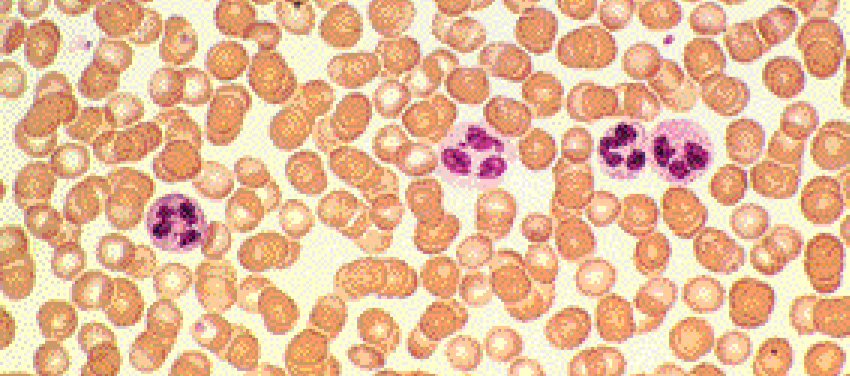
Imagem: Fotografia microscópica. Inúmeras esferas aglomeradas de cor marrom-claro, com três esferas rosas com esferas menores dentro de cor roxa.  Fim da imagem.

12
UNIDADE 1. A vida que não vemos

Lava uma mão, lava outra
Uma
Lava outra, lava uma
Lava outra, lava uma mão
Lava outra mão, lava uma mão
Lava outra mão
Lava uma
Depois de brincar no chão de areia a tarde inteira
Antes de comer, beber, lamber, pegar na mamadeira
Lava uma (mão), lava outra (mão)
Lava uma, lava outra (mão)
Lava uma
A doença vai embora junto com a sujeira
Verme, bactéria, mando
embora embaixo da torneira
Água uma, água outra
Água uma (mão), água outra
Água uma
[…]
LEGENDA: Arnaldo Antunes. Lavar as mãos (Mão), do álbum Castelo Rá-Tim-Bum. São Paulo: Velas, 1995. FIM DA LEGENDA.
13
Boxe complementar:
Vamos conversar
- O que as crianças mostradas na imagem estão fazendo?
- Identifique na canção versos que falam sobre:
• Quando devemos lavar as mãos.
• O que acontece quando lavamos as mãos.
- Lavar as mãos é importante? Por quê?
- Há seres vivos na sujeira das mãos? É possível enxergá-los?
Fim do complemento.
14
Investigar o assunto

O menor de todos
Há uma diversidade muito grande de seres vivos. Você já parou para se perguntar qual é o menor de todos eles? Será que é possível vê-lo?

LEGENDA: Os elementos da imagem não estão na mesma proporção. Cores fantasia. FIM DA LEGENDA.
O que você vai fazer
Investigar o que as pessoas sabem sobre os menores seres vivos que habitam o planeta.
Como você vai fazer
- Pergunte a colegas, parentes, vizinhos e conhecidos se eles sabem quais são os menores seres vivos do planeta. Escolha de duas a três pessoas para realizar uma breve entrevista.

- Leia o questionário acima e copie as perguntas em seu caderno. Você pode acrescentar perguntas, caso tenha curiosidade de saber algo mais sobre esses seres vivos. Pergunte também como são esses seres vivos.
- Organize e copie as perguntas em um bloco de anotações. Você vai levá-lo para registrar as respostas no dia das entrevistas.
15
- Na sala de aula, o professor vai montar um quadro como o do modelo abaixo. Ele será usado para organizar os dados obtidos por toda a turma.
Tabela: equivalente textual a seguir.
|
Nome do ser vivo |
Nº de pessoas |
Total |
|
1. Formiga |
I I I |
3 |
|
2. Pulga |
I I |
2 |
|
3. Ácaro |
I |
1 |
|
4. Bolor |
I I I |
3 |

- Cada estudante vai dizer o que descobriu em suas pesquisas.
- Observe os resultados e discuta-os com os colegas.
Para você responder
- Qual ser vivo foi mencionado o maior número de vezes em todas as entrevistas?
- As respostas das pessoas foram semelhantes ou muito diferentes?
- Quais seres vivos citados na entrevista você já viu?
- Quais seres vivos citados você conseguiria ver a olho nu?

- Em sua opinião, qual o
menor
ser vivo do planeta? Descreva-o para seus colegas.

- Por que você acha que é difícil as pessoas conhecerem os menores seres vivos do planeta?
16
Capítulo 1. A invenção do microscópio
De todos os instrumentos utilizados por pesquisadores, o microscópio é um dos que mais trouxeram avanços ao modo como conhecemos o mundo.
Os microscópios são utilizados, por exemplo, em salas de aula, na indústria e em pesquisas. Eles ampliam a imagem de seres vivos, materiais e objetos, permitindo ver detalhes que seriam invisíveis a olho nu.
A construção de microscópios
O item fundamental para a construção de um microscópio óptico é a lente. Você já deve ter visto lentes em muitos objetos, como óculos e lupas.
As lentes são objetos feitos de materiais transparentes, que ampliam ou distorcem imagens de um corpo quando olhamos através delas.

LEGENDA: A lente da lupa produz uma imagem ampliada dos objetos. FIM DA LEGENDA.

- É correto dizer que as lentes aumentam os objetos? Justifique.
O ser humano conhece o funcionamento das lentes há mais de 2 mil anos, mas somente a partir de 1660, usando lentes de melhor qualidade e combinando as lentes de aumento, foi possível obter ampliações ainda maiores. Com base nesse conhecimento, foram criados os primeiros microscópios ópticos.
Boxe complementar:
Hora de acessar
- Micróbios da floresta. Canal Butantan. Disponível em:
http://fdnc.io/etP. Acesso em: 27
jan.
2021.
O vídeo mostra como o planeta Terra está repleto de seres pequenos: alguns deles nós enxergamos quando nos aproximamos; outros, quando usamos lupas. E há milhares de seres muito pequenos, que só enxergamos com a ajuda de aparelhos como os microscópios.
Fim do complemento.
17
ÁLBUM de Ciências
Microscópio óptico
O microscópio óptico é utilizado para ampliar imagens e observar estruturas muito pequenas que, geralmente, não podem ser visualizadas sem ele. Esse instrumento utiliza luz visível e um sistema de lentes para ampliar as imagens.
Observe abaixo as partes que o constituem.

LEGENDA: Modelo simples de microscópio óptico. FIM DA LEGENDA.
18
A descoberta do mundo microscópico
Antes da invenção dos microscópios, as pessoas propunham diversas hipóteses a respeito da composição dos seres vivos, tentavam entender o que provocavam certas doenças e como elas se desenvolviam, mas não tinham meios para investigar essas questões. Com os microscópios, os pesquisadores começaram a observar outras formas de vida, muito pequenas, além de detalhes da composição do corpo dos seres vivos, de objetos e de materiais.
O pesquisador inglês Robert Hooke fabricou microscópios ópticos e fez várias descobertas acerca dos microrganismos. Ele construiu microscópios com duas e com três lentes na tentativa de aperfeiçoar esse instrumento.

LEGENDA: Microscópio de duas lentes desenvolvido por Robert Hooke no século XVII. A lente ocular fica no topo do microscópio e há uma lente objetiva, abaixo, perto da amostra a ser analisada. O sistema de iluminação utilizava um globo de vidro cheio de líquido para projetar a luz da chama de uma lamparina na amostra. FIM DA LEGENDA.

- Hooke se destacou pela forma cuidadosa como descrevia e desenhava os seres vivos, além do seu
esforço
em compreender a função de cada parte desses pequenos seres.
- O desenvolvimento do microscópio foi importante para o estudo da vida? Por quê?

LEGENDA: Gravura de uma pulga vista ao microscópio de lentes ópticas, feita por Robert Hooke, em 1665. FIM DA LEGENDA.
19

LEGENDA: Representação de Leeuwenhoek fazendo observações em seu microscópio. Note que ele direciona o microscópio para a fonte de luz. FIM DA LEGENDA.

LEGENDA: Microscópio de Leeuwenhoek desenvolvido no século XVII. FIM DA LEGENDA.
Um cientista holandês chamado Antonie van Leeuwenhoek também construiu seus próprios microscópios e descobriu muitos seres minúsculos diferentes. Ele os chamou de animálculos, o que significa “animais muito pequenos”.
Desde então, esses equipamentos foram cada vez mais aperfeiçoados. Atualmente, existem diferentes tipos de microscópio que permitem visualizar muitos detalhes dos seres vivos. Os microscópios eletrônicos, como o que produziu a imagem abaixo, estão entre os mais potentes.
Enquanto os microscópios ópticos produzem imagens com ampliações de até 400 vezes o tamanho original, os microscópios eletrônicos produzem imagens com ampliações de até 2 milhões de vezes.

Comprimento: 1 cm.
LEGENDA: A imagem acima mostra uma mosca e detalhes da estrutura da cabeça e dos olhos com ampliação de 59 vezes, obtidos por um microscópio eletrônico. Imagem colorida artificialmente. FIM DA LEGENDA.

- Os microscópios se modificaram ao longo do tempo. Em sua opinião, qual o propósito dessas modificações?
20
Capítulo 2. As células
Ao observar um pedaço de cortiça ao microscópio óptico, Robert Hooke percebeu que ela era formada por inúmeras pequenas câmaras vazias, que ele chamou de células.
Ele observou também partes vivas de algumas plantas e verificou a presença das mesmas câmaras, só que, nesse caso, preenchidas por um material gelatinoso.
Outros pesquisadores perceberam o potencial do microscópio e passaram a utilizá-lo para observar partes de animais e plantas. Eles também viram que as células estavam presentes em todos os seres vivos examinados.
Depois de anos de muitas descobertas, os cientistas chegaram à conclusão de que todos os seres vivos são formados por células.

LEGENDA: Reprodução de desenhos feitos por Robert Hooke em 1667. Acima, ilustração das células da cortiça; ao lado, ramo da planta. FIM DA LEGENDA.

- Observe a imagem que mostra um corte de folha observado por meio de um microscópio óptico moderno. Foram usados corantes para tingir o interior da folha.

Comprimento: 60 cm.
LEGENDA: Planta aquática elodea. FIM DA LEGENDA.
LEGENDA: Corte de folha visto no microscópio óptico. Aumento de 400 vezes. FIM DA LEGENDA.
- Quais são as semelhanças entre a fotografia do corte de folha e a ilustração elaborada por Hooke que representa a cortiça?
- O que são essas “câmaras” que formam a folha?
21

Comprimento: 50 cm.
LEGENDA: O girassol é uma planta formada por muitas células, que se organizam em estruturas diferentes, como a flor, a folha, o caule e a raiz. FIM DA LEGENDA.
Os seres vivos são formados por células
Os seres vivos unicelulares, como as bactérias, são constituídos por uma única célula, que desempenha todas as funções do organismo. Os seres vivos pluricelulares são formados por mais de uma célula. Neles, cada conjunto de células pode ter funções específicas.
Tanto a célula de um ser unicelular quanto as células que formam os seres pluricelulares precisam de alimento. As células usam os alimentos como fonte de energia para suas atividades e como material para formar novas células. Elas também produzem e eliminam resíduos.
As células se originam de outra célula. Nos seres pluricelulares, quando elas se multiplicam, promovem o crescimento de estruturas ou substituem as células que morrem ao longo da vida.
- Leia o texto, observe a imagem de um ser unicelular e responda às questões no caderno.
Os seres unicelulares apresentam um ciclo de vida, ou seja, eles nascem, crescem, se desenvolvem, podem se reproduzir e, após algum tempo, morrem.

LEGENDA: Paramécio em processo de divisão celular visto ao microscópio. Aumento de 139 vezes. FIM DA LEGENDA.
- Podemos dizer que um ser unicelular é um ser vivo?
- Qual característica de um ser vivo está representada na imagem?
- Observe a imagem a seguir, leia a legenda e responda à questão no caderno.
- A célula mostrada na imagem pertence a um animal ou a uma planta?

LEGENDA: Algumas células possuem cloroplastos, estruturas responsáveis pela produção de alimento na célula. Folha vista ao microscópio óptico. Aumento de 643 vezes. FIM DA LEGENDA.
22
Organização das células
As células que compõem um ser vivo pluricelular têm funções diferentes, como revestimento, digestão e secreção de substâncias. Geralmente, a forma das células está relacionada à sua função.

LEGENDA: Esquema representando a camada mais superficial da pele. A forma, a disposição e a quantidade de células nessa camada ajudam a proteger o corpo humano de microrganismos, toxinas e da perda de líquidos. Cores fantasia. FIM DA LEGENDA.
Em grande parte dos organismos pluricelulares, as células estão organizadas de acordo com sua função, formando diferentes estruturas que garantem o funcionamento do organismo como um todo.
- A imagem a seguir mostra um corte da raiz de uma planta de milho, vista ao microscópio óptico. Observe a imagem e responda às questões no caderno.

LEGENDA: Representação da raiz da planta de milho. FIM DA LEGENDA.
LEGENDA: Parte da raiz da planta do milho vista ao microscópio óptico. Aumento de 21 vezes. FIM DA LEGENDA.
- As células que formam a planta são todas iguais? Explique.
- Você acha que essas células têm as mesmas funções na planta? Por quê?
23
ÁLBUM de Ciências
Composição do organismo
As células podem apresentar diferentes formas, tamanhos e funções. Ao se agruparem, o conjunto de células que desempenha a mesma função forma um tecido.
Tecidos diferentes, com funções específicas, mas que atuam juntos, formam um órgão.
Os órgãos, funcionando de forma coordenada, compõem um sistema. Juntos, os sistemas formam um organismo.
Com a integração entre os sistemas, o organismo pode interagir com o meio externo, se alimentar, se reproduzir e realizar outras funções vitais .
Observação: Os elementos da imagem não estão representados na mesma proporção. Cores fantasia. Fim da observação.

LEGENDA: Representação esquemática de células musculares, tecido muscular e coração do tuiuiú, que é um organismo. FIM DA LEGENDA.

Com a ajuda de um adulto, pesquise um exemplo de célula, de tecido, de órgão e de sistema do corpo humano.
24
Capítulo 3. Os vírus e as bactérias
Por meio da invenção dos microscópios e do trabalho de vários pesquisadores que utilizam esse instrumento, descobriu-se a existência de uma grande diversidade de microrganismos, como bactérias, vírus, fungos e protozoários.
Os vírus
Os vírus são seres microscópicos, mas não são formados por célula e têm estrutura muito simples. Eles só conseguem viver e se reproduzir dentro de células de outros seres vivos. Por causa dessas características, não há consenso entre os cientistas se os vírus podem ser considerados seres vivos ou não.

LEGENDA: Pesquisador analisando amostra em um microscópio óptico. FIM DA LEGENDA.
Certos tipos de vírus vivem e se multiplicam no interior de outros seres vivos, como plantas e animais. Os fitovírus, por exemplo, são vírus que causam doenças em plantas. Muitos deles provocam a redução da produção e da qualidade de frutos, o desenvolvimento anormal da planta, além de afetar o processo pelo qual ela produz seu próprio alimento.

LEGENDA: Várias hortaliças são afetadas por vírus. A contaminação de lavouras pode prejudicar a produção de alimentos. FIM DA LEGENDA.

Altura: 30 cm.
LEGENDA: Os vírus também podem ser usados para obter resultados desejados. As tulipas geralmente têm apenas uma cor, mas as que apresentam duas cores são mais valorizadas no mercado. As tulipas com duas cores foram infectadas por um vírus que ataca algumas células, levando a surgir a segunda cor. FIM DA LEGENDA.
25
Nos seres humanos, a gripe, o sarampo, a dengue e a Covid-19 são alguns exemplos de viroses, isto é, doenças provocadas por vírus.
Grande parte dos vírus pode ser transmitida pelo ar, pela água, pelo contato com pessoas doentes ou com objetos contaminados, ou ainda por meio da picada de insetos.

LEGENDA: Alguns vírus (em vermelho) atacando uma bactéria (em azul). Imagem obtida com microscópio eletrônico, colorizada artificialmente. Aumento de 40 mil vezes. FIM DA LEGENDA.

LEGENDA: Vírus causadores da gripe (em azul) atacando células do sangue (em vermelho). Imagem obtida com microscópio eletrônico, colorizada artificialmente. Aumento de 6 800 vezes. FIM DA LEGENDA.
Com os avanços da Ciência, os vírus têm sido utilizados também na indústria e na área da saúde. Veja um exemplo a seguir.

LEGENDA: A cientista brasileira Margareth Ozelo estuda como há vírus que podem auxiliar no tratamento de pacientes com hemofilia . Fotografia de 2021. FIM DA LEGENDA.

- Se os vírus não têm células, por que alguns pesquisadores defendem a ideia de que eles são seres vivos?
Boxe complementar:
Hora da leitura
- Viagem ao mundo dos micróbios, de Samuel Murgel Branco, Editora Moderna, 1992.
Fim do complemento.
26
As bactérias
As bactérias são seres vivos microscópicos formados por uma única célula. Elas estão entre os menores seres vivos da Terra.
Como as bactérias são invisíveis a olho nu, é difícil notarmos a presença delas. Existem muitos tipos de bactéria. Elas podem estar no ar, na água, no solo e no corpo de outros seres vivos. Algumas vivem em locais onde o ser humano não conseguiria sobreviver, como em regiões profundas do oceano, perto de vulcões e também em locais extremamente frios.
A maioria das bactérias não provoca nenhum mal aos seres humanos, mas muitas pessoas já devem ter ouvido falar em malefícios que elas causam. As cáries, o cheiro de suor e de chulé, e doenças como o botulismo, o tétano e a cólera são provocados por bactérias. A ingestão de alimentos contaminados por certos tipos de bactéria, por exemplo, pode causar vômitos e diarreia.

LEGENDA: Bactérias que vivem na pele humana. Imagem obtida com microscópio eletrônico, colorizada artificialmente. Aumento de 5 000 vezes. FIM DA LEGENDA.

LEGENDA: A bactéria Escherichia coli geralmente habita o intestino humano sem causar problemas de saúde. No entanto, em outras regiões do corpo é capaz de provocar infecções. Imagem obtida por microscópio eletrônico. Ampliação de 4 000 vezes. FIM DA LEGENDA.
- Leia o texto e responda às questões no caderno.
Na pele habitam milhões de bactérias
A pele humana abriga uma imensa diversidade de bactérias. Diferentemente do que muitos pensam, as bactérias que vivem em nossa pele são, em sua maioria, inofensivas. Muitas delas, inclusive, são essenciais para a saúde da pele.
- Se muitas bactérias são inofensivas para o ser humano, por que é recomendável lavar as mãos?

- Bactérias e vírus são microrganismos. Como é possível diferenciá-los?
- Se muitas bactérias são inofensivas para o ser humano, por que é recomendável lavar as mãos?
27
Relações entre bactérias e outros seres vivos
A maioria das bactérias gera benefícios ou não é danosa a outros seres vivos.
Existem bactérias que habitam o intestino de animais e auxiliam na digestão do alimento, por exemplo. Diversas bactérias habitam o solo e o tornam mais rico em nutrientes, facilitando o crescimento das plantas. Outras participam do processo de decomposição da matéria orgânica.
No intestino humano vivem muitos tipos de bactéria que fazem parte do processo de digestão, produzem vitaminas e evitam o aumento do número de bactérias causadoras de doenças. A alimentação saudável, rica em frutas e hortaliças, beneficia as bactérias que atuam em nosso intestino.
Outro papel importante das bactérias para o ser humano é na produção de alguns alimentos, como o queijo, o iogurte e o vinagre. Até a produção de alguns remédios é feita com o uso de bactérias.

LEGENDA: A ação das bactérias no leite é fundamental para a produção de diversos tipos de queijo. FIM DA LEGENDA.
Observação: LEGENDA: As imagens nesta página não estão na mesma proporção. Fim da observação.

LEGENDA: Diferentes tipos de microrganismo são utilizados na produção do chocolate derivado do cacau. As bactérias são responsáveis pelo processo que dá o sabor característico ao chocolate. FIM DA LEGENDA.
28
Leia o texto e responda às questões em seu caderno.
Bactérias que podem fazer chover
Além de vapor e gotículas de água, as nuvens também contêm bactérias vivas. Algumas delas podem facilitar a transformação da água em gelo.
Uma vez que gotas se congelam em torno desses microrganismos, eles ficam mais pesados e “caem” da nuvem.
Esse gelo pode derreter e se tornar pingos de chuva ou formar flocos de neve. Isso significa que essas pequenas formas de vida podem contribuir para a formação da chuva.

LEGENDA: A bactéria mostrada na imagem (Pseudomonas aeruginosa) pode facilitar a formação de flocos de neve. Imagem obtida por microscópio eletrônico, colorizada artificialmente. Aumento de 9 024 vezes. FIM DA LEGENDA.
- Localize no texto o que acontece com o gelo que estava em volta do microrganismo após ele cair da nuvem.
- Como você relaciona a variação da quantidade dessas bactérias no ar e o ambiente dos seres vivos? Em sua opinião, eles podem ser afetados?
Escreva no caderno exemplos em que as bactérias e os vírus trazem malefícios aos seres humanos.
A diarreia é uma doença bastante comum, que atinge principalmente crianças, e pode ser transmitida por diversos tipos de bactéria e vírus.
- Faça uma pesquisa e descubra alguns dos microrganismos que causam a diarreia.
- Indique algumas formas de prevenir a diarreia.
Boxe complementar:
Hora da leitura
- Dudu e a tagarela Bac, Alane Beatriz Vermelho, Vieira & Lent, 2011.
Fim do complemento.
29
- Observe a imagem e faça o que se pede.

FONTE: Elaborado com base em: MIOTO, Ricardo. Pele tem centenas de tipos de bactérias. Folha de S.Paulo , 29 maio 2009. Ciência.
- Escreva com suas palavras o que significa proliferar. Se não souber, consulte um dicionário impresso ou digital.
- Como os microrganismos que vivem na pele humana estão classificados na imagem?
- Identifique em qual local há mais tipos de microrganismos. Em seguida, relacione esse local ao tipo de ambiente em que ele está enquadrado.
- Cada planta ou animal abriga uma grande quantidade de minúsculos seres, e a esse conjunto de microrganismos chamamos microbioma. A ciência tem revelado, cada vez mais, os benefícios que os microbiomas trazem para o meio ambiente e para os seres vivos em que vivem.
- Cite alguns benefícios do microbioma humano.
30
Capítulo 4. Os fungos e os protozoários
Os fungos
Fungos são seres vivos que podem ser formados por uma única célula, como as leveduras, ou por várias células, como os cogumelos e os bolores.

LEGENDA: Leveduras são fungos unicelulares de forma ovalada. Imagem obtida com microscópio eletrônico, colorizada artificialmente. Aumento de 3 200 vezes. FIM DA LEGENDA.

LEGENDA: Diâmetro do chapéu: 10 cm. FIM DA LEGENDA.
LEGENDA: Cogumelos são fungos formados por várias células, ou seja, são pluricelulares. FIM DA LEGENDA.
Algumas características externas, como a forma de se fixar no solo e o fato de não se locomoverem, fazem com que os fungos, muitas vezes, sejam confundidos com plantas. Porém, ao contrário das plantas, eles não produzem seu próprio alimento.
A maioria dos fungos se alimenta de restos de seres vivos, como folhas ou animais mortos. Por isso, assim como as bactérias, os fungos são importantes na decomposição de matéria orgânica.
Alguns fungos vivem associados a raízes de plantas e as ajudam a absorver água e nutrientes do solo. Outros vivem no corpo de animais e plantas e podem causar doenças.

LEGENDA: A micorriza é uma associação entre certos fungos e as raízes de algumas plantas que traz muitos benefícios para ambos. FIM DA LEGENDA.
- Os bolores são também conhecidos como mofo. Você já viu algum? No caderno, descreva como ele era e onde estava crescendo.
31
O corpo dos cogumelos e dos bolores é composto de fios compridos e finos, microscópicos, chamados hifas. As hifas crescem em meio ao solo, a restos de alimento, em troncos caídos, entre outros locais.
As partes desses organismos que crescem acima da superfície e que conseguimos ver são as estruturas relacionadas à reprodução, conhecidas como corpo de frutificação.
Observação: Os elementos da imagem não estão representados na mesma proporção. Cores fantasia. Fim da observação.

LEGENDA: Nos cogumelos e bolores, grande parte do organismo fica abaixo da superfície. As partes que ficam acima da superfície são estruturas de reprodução. FIM DA LEGENDA.
Os fungos e o ser humano
Alguns fungos são utilizados na alimentação, como o champignon e o shimeji. As leveduras são usadas como fermento na produção de pães, bebidas alcoólicas e etanol, este usado como combustível de automóveis.
Alguns fungos também são usados na produção de antibióticos, isto é, remédios usados para causar a morte de bactérias que provocam doenças em outros seres vivos.

Diâmetro do corpo de frutificação: 2 cm.
LEGENDA: O shimeji é um cogumelo usado na alimentação. FIM DA LEGENDA.
Diâmetro da placa: 10 cm.
LEGENDA: A mancha clara no centro da placa de cultivo de microrganismos são fungos cultivados em laboratório para a produção de penicilina, um antibiótico. FIM DA LEGENDA.
32
Atividade prática
Experimento
Pão mofado
Você já viu um alimento estragado ou sentiu seu cheiro? Em quais condições um pão estraga mais facilmente?
O que você vai fazer
Testar o que acontece com o pão deixado em diferentes condições de umidade, temperatura e luminosidade.
Material
- 6 sacos plásticos transparentes
- 6 fatias de pão
- 6 bolinhas de algodão
- água
- 6 elásticos
- 6 etiquetas

Como você vai fazer
- Reunidos em grupos, coloquem uma fatia de pão em cada saco plástico.
- Umedeçam três bolinhas de algodão com água. Coloquem as bolinhas de algodão úmido em três sacos plásticos e as bolinhas de algodão seco nos outros três sacos.
- Fechem os sacos plásticos com os elásticos.
- Em seguida, coloquem um saco com algodão úmido e um saco com algodão seco em três locais diferentes: no refrigerador, no interior de um armário e em outro local escolhido pelo grupo. Observem se esse local apresenta uma ou mais características que diferem dos demais, considerando temperatura e incidência de luz.
- Anotem na etiqueta a data, se o algodão estava úmido ou seco e o local onde o pão foi colocado.


33
Levante suas hipóteses

- Em que condições você acha que o pão vai estragar mais rapidamente? Por quê?
Agora, continue seu experimento com os passos a seguir.
- Observem, durante cinco dias, o que acontece com as fatias de pão em cada um desses locais.
- No caderno, façam um quadro como o do
modelo
abaixo. Lembrem-se de anotar a data da observação e de indicar o terceiro lugar escolhido pelo grupo. Para ter um registro bem completo, vocês também podem desenhar o aspecto de cada pão ou tirar fotografias.
Tabela: equivalente textual a seguir.
Data
Refrigerador (lugar frio e sem luz)
Interior de um armário (à temperatura ambiente e sem luz)
Local escolhido pelo grupo
Algodão úmido
Algodão seco
Algodão úmido
Algodão seco
Algodão úmido
Algodão seco
Para você responder

- Passados cinco dias de observação, discuta com os colegas do seu grupo as questões a seguir. Depois, escreva no
caderno
as conclusões de vocês.
a) Em que condições o pão estragou mais rapidamente? Como ele ficou?
b) Em que condições o pão estragou mais lentamente? Como ele ficou?
c) Que explicação vocês dariam para o que foi observado?

- Discutam os resultados com o restante da turma. Revejam as conclusões, levando em consideração os resultados de todos os grupos.


- Com a ajuda de um adulto, identifique as condições de luz, de temperatura e de umidade em que os pães são armazenados na sua casa. Você considera essas condições adequadas?

34
Para ler e escrever melhor
O texto descreve o maior ser vivo do mundo.
O maior ser vivo do mundo
O maior ser vivo do planeta não é um animal nem uma planta: é um fungo. Seu nome científico é Armillaria solidipes, e ele é conhecido como cogumelo-mel, por causa de sua coloração marrom-amarelada. Esse organismo cresce no estado de Michigan, nos Estados Unidos, e se estende por uma área equivalente a mais de 1.000 campos de futebol!
Não é muito fácil ver esse organismo na superfície, pois a maior parte do seu corpo é composta de hifas que se espalham em meio ao solo. Elas se alastram por muitos quilômetros.
Para o fungo se alimentar, as hifas fixam-se nas raízes de árvores e liberam substâncias capazes de quebrar os componentes da madeira em partes menores para, depois, absorvê-los. Muitas árvores ficam fracas por causa da ação do fungo e acabam morrendo.
A parte visível desse fungo são os cogumelos, que aparecem no outono. Nessa época do ano, é possível observar muitas dessas estruturas reprodutivas, que brotam dos filamentos e chegam a atingir 20 centímetros de altura cada uma.

LEGENDA: Altura: 20 cm. FIM DA LEGENDA.
LEGENDA: Cogumelos-mel. FIM DA LEGENDA.

LEGENDA: Árvores afetadas pelo cogumelo-mel nos Estados Unidos, em 2019. FIM DA LEGENDA.
35
Analise
- Entre as características indicadas no quadro a seguir, escreva no
caderno
aquelas que foram apresentadas no texto para descrever o cogumelo-mel.
Estrutura do corpo
Textura
Alimentação
Nome
Tamanho
Odor
Coloração
Localização
Organize
- Copie o quadro abaixo no
caderno
e complete-o, escrevendo as informações que você localiza no texto sobre o cogumelo-mel.
Tabela: equivalente textual a seguir.
Armillaria solidipes
Onde vive o maior organismo
De que se alimenta
Como é seu corpo
Observação: Os elementos da imagem não estão representados na mesma proporção. Cores fantasia. Fim da observação.
Escreva
- Escreva um texto no caderno que descreva o fungo orelha-de-pau com base na imagem e nas informações apresentadas a seguir.
- Nome científico: Pycnoporus sanguineus.
- Comum no Brasil. Costuma aparecer em regiões alteradas pela ação humana.
- Alimenta-se de madeira morta.
- Pode atingir 15 cm de largura.

36
Os protozoários
Os protozoários são seres microscópicos unicelulares. Na maioria dos casos, não produzem seu próprio alimento e alimentam-se de outros seres vivos ou de restos deles.
Protozoários podem ser de vida livre e habitar o mar, a água doce ou o solo úmido. Alguns vivem dentro de outros seres vivos. No interior do intestino de cupins e bois, por exemplo, há protozoários que os ajudam na digestão de alguns tipos de alimento.
Eles têm diferentes estruturas de locomoção, como cílios, flagelos e projeções do corpo.

LEGENDA: O paramécio é um protozoário de água doce que se locomove pelo batimento dos cílios. Imagem obtida com microscópio eletrônico, colorizada artificialmente. Aumento de 640 vezes. FIM DA LEGENDA.

LEGENDA: O tripanossomo é um protozoário flagelado que causa a doença de Chagas. Imagem obtida com microscópio eletrônico, colorizada artificialmente. Aumento de 600 vezes. FIM DA LEGENDA.

LEGENDA: A ameba é um protozoário de água doce que se desloca projetando partes da célula. Imagem obtida com microscópio eletrônico, colorizada artificialmente. Aumento de 160 vezes. FIM DA LEGENDA.
- Observe as imagens abaixo e responda no caderno.

Elementos representados fora de proporção. Cores fantasia.
- Qual dos protozoários acima se locomove pelo batimento de cílios?
- Como se locomove o protozoário da imagem B?
- Quantas células tem cada protozoário das imagens?
Boxe complementar:
Hora de acessar
- Micromundo – O mundo microscópico. Canal Butantan. Disponível em: http://fdnc.io/fpM. Acesso em: 24 jun. 2022. O vídeo apresenta registros reais de diversas funções vitais de alguns protozoários invisíveis a olho nu e de suas relações com o meio ao seu redor.
Fim do complemento.
37
Relações entre protozoários e outros seres vivos
Os protozoários alimentam-se principalmente de bactérias e fungos, e servem de alimento para outros seres. Dessa forma, assim como ocorre com os demais organismos, os protozoários participam da cadeia alimentar, ou seja, eles fazem parte das relações alimentares que ocorrem entre os seres vivos de determinado ambiente.
No processo de tratamento da água que ocorre em estações de tratamento de esgoto, alguns tipos de protozoários são utilizados para retirar bactérias e partículas sólidas da água.
Alguns protozoários podem causar doenças em plantas e animais. No ser humano, por exemplo, um protozoário transmitido por mosquitos pode causar a malária; água e alimentos contaminados podem transmitir amebíase. Em cães, certos protozoários podem causar doenças graves, como a babesiose.

LEGENDA: Imagem obtida por microscópio eletrônico, colorizada artificialmente. Aumento de 450 vezes. FIM DA LEGENDA.

Carrapato-vermelho-do-cão, que mede 0,5 cm de comprimento.
LEGENDA: A babesiose é transmitida pelo carrapato e afeta células do sangue de cães. FIM DA LEGENDA.

- Leia o texto, observe as imagens e responda às questões no caderno.
A giárdia é um protozoário que pode viver no intestino humano e causar uma doença chamada giardíase. A transmissão ocorre pela ingestão de água ou alimentos contaminados. Os sintomas principais são diarreia e dor abdominal.
- A giárdia é um organismo formado por uma ou por muitas células?
- Observe a imagem e identifique a estrutura de locomoção da giárdia. De que forma você acha que ela se locomove no intestino humano?
- Com base no texto, como você acha que é possível prevenir a giardíase?

LEGENDA: Giárdia vista ao microscópio eletrônico, colorizada artificialmente. Aumento de 1 200 vezes. FIM DA LEGENDA.
38
Capítulo 5. Os microrganismos e a saúde
Os microrganismos nocivos à saúde podem entrar em nosso corpo de diversas formas. Conhecer essas formas de transmissão é uma maneira de se prevenir contra as doenças causadas por microrganismos.
Água ou alimentos contaminados
Alguns microrganismos patogênicos podem contaminar os alimentos e a água. Se forem ingeridos, eles podem provocar doenças como o cólera e a salmonelose, causadas por bactérias, e a amebíase e a giardíase, causadas por protozoários. Essas doenças têm como principais sintomas diarreia e dores abdominais.
Os elementos da imagem não estão na mesma proporção.

LEGENDA: A bactéria que causa a salmonelose se aloja em alguns alimentos de origem animal, como ovos, carne de frango e leite, e também em alimentos de origem vegetal, como grãos. FIM DA LEGENDA.
- A amebíase é uma doença transmitida pela ingestão de água ou de alimentos contaminados pela ameba causadora da doença.
- Faça uma pesquisa e descubra outra doença transmitida da mesma forma que a amebíase.

- Converse com um colega sobre formas possíveis de prevenir essas doenças.
- Faça uma pesquisa e descubra outra doença transmitida da mesma forma que a amebíase.

LEGENDA: A amebíase é causada pelo protozoário Entamoeba histolytica. Imagem obtida por microscópio óptico. Aumento de 1 150 vezes. FIM DA LEGENDA.
39
Contato com a pele
Há fungos presentes no ar que se alimentam das células mortas da pele. Esse tipo de fungo pode causar uma doença conhecida como micose.
Outros microrganismos entram no corpo através de feridas na pele. É o caso do tétano, doença causada por uma bactéria e que pode ser grave se não houver tratamento adequado.

LEGENDA: Manter os calçados limpos e secos, assim como lavar e enxugar bem os pés, são hábitos que evitam a instalação dos fungos que causam a micose. FIM DA LEGENDA.
Picada de insetos
Muitas doenças causadas por microrganismos são transmitidas pela picada de insetos. É o caso de dengue, zika, chikungunya e febre amarela, que são causadas por vírus e podem ser transmitidas pelo mosquito Aedes aegypti. A malária e a doença de Chagas, causadas por protozoários, também são transmitidas por insetos.

Comprimento: cerca de 0,5 cm.
LEGENDA: Ao picar uma pessoa, um mosquito contaminado pode inserir microrganismos patogênicos na corrente sanguínea da vítima. Na fotografia, o mosquito Aedes aegypti. FIM DA LEGENDA.

Comprimento: cerca de 1 cm.
LEGENDA: O inseto barbeiro transmite o protozoário causador da doença de Chagas. FIM DA LEGENDA.
40
Gotículas de saliva
Certos microrganismos que causam doenças estão presentes na saliva e podem ser lançados no ambiente sempre que as pessoas doentes tossem ou espirram. Quando essas gotículas atingem o nariz, os olhos ou a boca de outra pessoa, ela pode adoecer. Essa é a forma de transmissão de doenças como gripe, resfriados, sarampo e catapora, causadas por vírus.

LEGENDA: Quando espirramos, liberamos milhares de gotículas de saliva. FIM DA LEGENDA.
As gotículas de saliva podem cair sobre objetos, como maçanetas, cadeiras e mesas. Assim, ao tocarem esses objetos, outras pessoas podem ser contaminadas.
Da mesma forma, pessoas podem ser contaminadas ao compartilhar utensílios de cozinha, como copos e garfos, com uma pessoa doente. Por isso, esses utensílios precisam ser higienizados corretamente antes de serem utilizados.
- Copie o quadro a seguir no
caderno
e complete as lacunas com as informações que estão faltando.
Tabela: equivalente textual a seguir.
Doença
Microrganismo causador
Transmissão
Dengue
Vírus
Malária
Picada de inseto
Gripe
Vírus
Micose
Contato com a pele
Doença de Chagas
Protozoário
Cólera
Ingestão de água contaminada
41
Prevenção de doenças
Os microrganismos que causam doenças podem estar nos mais diversos locais, muitos deles sujos, onde costumam se proliferar. Por isso, é importante cuidar da limpeza dos ambientes e evitar frequentar lugares sujos, que possam estar contaminados.
É importante lavar bem os alimentos antes de ingeri-los e consumir apenas água tratada. Ferver a água antes de bebê-la ajuda a eliminar os microrganismos causadores de doenças.
Também deve-se evitar colocar as mãos sujas em machucados, no nariz, na boca e nos olhos. Sempre que for espirrar, coloque um lenço ou o braço na frente da boca. Quando espirrar nas mãos, lave-as em seguida para evitar contaminar os objetos que tocar.
Hábitos de higiene, como lavar as mãos antes das refeições e após usar o banheiro, tomar banho, cortar as unhas, manter roupas e sapatos limpos e escovar os dentes após as refeições, são muito importantes para a manutenção da saúde.

LEGENDA: Ao espirrar, use a dobra do braço para evitar espalhar gotículas de saliva no ambiente. FIM DA LEGENDA.

- Como você previne doenças no seu dia a dia?
- Observe o cartaz abaixo e responda às questões em seu caderno.

LEGENDA: Cartaz produzido pela Agência Estadual de Vigilância em Saúde do estado da Paraíba, em 2018. FIM DA LEGENDA.
- Qual é o tema do cartaz?
- Em sua opinião, qual é a importância da mensagem desse cartaz?
42
- Faça uma pesquisa sobre a frieira (pé-de-atleta) e identifique as formas de transmissão da doença. Em seguida, escreva uma mensagem e faça um desenho mostrando como é possível preveni-la.
- Veja a sequência de ações que o menino realizou antes de ir à escola e responda às questões em seu caderno.

- Você acha que o menino está tomando cuidado com a própria higiene?
- Que conselhos você daria a ele?
- Por que é importante seguir esses conselhos?
- Indique, em seu caderno, a relação entre as formas de transmissão das doenças (números) e os meios de preveni-las (letras).
Formas de transmissão
- Picada de inseto.
- Ingestão de água contaminada.
- Contato com a pele e com machucados.
- Contato com gotículas de saliva.
- Ingestão de alimentos contaminados.
Meios de prevenção
a. Lavar as mãos após espirrar.
- Combater o mosquito transmissor.
c. Ferver a água antes de beber.
- Lavar bem os alimentos antes de ingeri-los.
- Manter a higiene corporal e do ambiente.

- A Covid-19 é uma doença transmitida principalmente por meio do contato com pequenas gotículas que contêm o vírus SARS-Cov-2, que são expelidas por pessoas infectadas. Uma das maneiras de prevenir a doença é por meio do uso de máscaras.
- De que forma essa medida pode evitar a transmissão da doença?
43
Atividade prática
Exposição de arte
Pequenos seres vivos
A riqueza de formas e de cores dos seres vivos costuma servir de inspiração para muitos artistas criarem suas obras de arte.
O que você vai fazer
Elaborar uma obra de arte inspirada em um ser vivo e organizar uma exposição.

LEGENDA: E. coli, escultura de vidro representando um microrganismo, feita pelo artista inglês Luke Jerram, em 2009. A escultura mede 105 cm de comprimento. FIM DA LEGENDA.
Como você vai fazer
- Escolha um dos seres vivos mencionados nas entrevistas do começo da unidade. Procure imagens dele em livros e na internet.
- Com base no que você descobriu em suas pesquisas, crie uma obra de arte inspirada nesse ser vivo. Pode ser uma escultura feita com sucata, uma colagem ou um desenho feito com lápis colorido, canetinhas hidrocor ou tintas guache, por exemplo.
- Dê um título à sua obra de arte e identifique-a com seu nome.
- O professor vai organizar uma exposição com as obras de arte da turma. Aproveite para ver o que os colegas produziram.

44
Atividade prática
Divulgação

Folheto educativo
O conhecimento sobre os microrganismos que causam doenças é muito importante para a saúde pública. É preciso que todas as pessoas se informem sobre as situações em que há risco de contrair doenças e tenham atitudes que ajudem a evitá-las, especialmente as doenças mais comuns no lugar onde se vive.
Uma maneira de ajudar é organizar campanhas educativas. Com informação adequada, é muito mais fácil agir de forma correta.
O que você vai fazer
Elaborar um folheto educativo sobre uma doença comum no seu bairro ou na sua cidade.
Como você vai fazer
Etapa 1: Levantando informações sobre a doença
- Entreviste algumas pessoas da sua comunidade para saber que doenças elas contraíram recentemente.

- Reúnam-se em grupos e escolham uma das doenças entre as mais citadas pelos entrevistados. Procurem informações sobre a doença selecionada em livros, em revistas ou na internet.
- Procurem também imagens que possam ajudar a informar as pessoas a respeito da doença e de sua prevenção.
Etapa 2: Levantando informações sobre o folheto educativo
- Com o professor, organizem uma visita a um posto de saúde da região. Observem os materiais de divulgação que estão disponíveis: cartazes, vídeos e folhetos. Se for possível, coletem alguns exemplares de folhetos educativos para servirem de inspiração para o que vocês vão produzir.
- Observem com mais atenção como são os folhetos educativos distribuídos nos postos de saúde. Reparem no tipo de informação que eles fornecem, se apresentam imagens, se têm muito texto, o tamanho das letras etc.
45
Etapa 3: Produzindo um folheto educativo
- Preparem um esboço do folheto. Planejem o tipo e o tamanho do papel que vocês vão utilizar, o tamanho da letra, a quantidade de figuras. Organizem as informações e as imagens que julgarem importantes e montem o folheto.
- Vocês podem tirar cópias dos folhetos e distribuí-las para as pessoas de sua comunidade. Se preferirem, montem o folheto no computador e divulguem-no em redes sociais virtuais ou aplicativos de mensagens.
Para você responder

- Após ter feito essa atividade, você aprendeu sobre as doenças que afetam sua comunidade? Você acha que esse aprendizado foi compartilhado com outras pessoas? Converse com a turma.

- Observe a ilustração abaixo, que mostra alguns meios de comunicação.

- Converse com os colegas sobre campanhas de prevenção de doenças que vocês já viram em outros meios de comunicação, como televisão, rádio, jornal, revista, outdoors etc. As doenças tratadas nessas campanhas são as mesmas que foram identificadas nas entrevistas realizadas?
- Que importância cada meio de comunicação tem na divulgação de informações sobre prevenção de doenças e cuidados com a saúde?

- Distribua o folheto que vocês produziram às pessoas que vivem em sua casa. Converse sobre a doença e formas de preveni-la.
46
Capítulo 6. Tecnologia a favor da saúde
As vacinas
Ao tomar uma vacina, nosso corpo produz defesas contra certos microrganismos que causam doenças. Assim, o corpo fica protegido caso entre em contato com esses microrganismos.
As primeiras formas de vacinação são muito antigas. Os chineses já faziam uso dessa prática há quase mil anos, e outros povos da Ásia e da África também desenvolveram técnicas semelhantes. Por meio dessas técnicas, eles buscavam provocar uma forma mais branda de certas doenças; assim, quando as pessoas eram infectadas novamente, não voltavam a adoecer, prevenindo-se das formas mais graves dessas doenças.
Mais tarde, na década de 1790, um médico inglês chamado Edward Jenner fez muitos experimentos com uma variedade mais branda da varíola e desenvolveu uma técnica que chamou de vacina. Até hoje ele é considerado o inventor das vacinas.

LEGENDA: Durante os primeiros anos de vida, as crianças são vacinadas contra muitas doenças. Agente de saúde aplicando vacina contra o sarampo em menino indígena do povo Haliti Paresí em Campo Novo dos Parecis, Mato Grosso, em 2018. FIM DA LEGENDA.
47
- Todos os anos, antes do início do inverno no Brasil, o Ministério da Saúde promove campanhas de vacinação contra a gripe. Observe o cartaz da campanha e responda no caderno.

LEGENDA: Cartaz de campanha nacional de vacinação contra a gripe do Ministério da Saúde, em 2020. FIM DA LEGENDA.
- O cartaz da campanha de vacinação reproduzido acima é voltado para quais grupos da população?
- No frio, os casos de gripe aumentam. Você acha que isso tem relação com a forma de transmissão da gripe? Por quê?
- Ana queria convencer sua avó a tomar a vacina contra a gripe. Para isso, disse que a vacina ajuda a tratar a doença. Você concorda com o argumento de Ana? Por quê?
Boxe complementar:
Hora de acessar
- Um cientista, uma história/Oswaldo Cruz. Canal Futura. Disponível em: http://fdnc.io/etV. Acesso em: 25 jan. 2021. O vídeo conta a história do médico sanitarista Oswaldo Cruz, que ajudou a eliminar a varíola e outras epidemias.
Fim do complemento.
48
Os medicamentos
Quando o corpo está doente, existem medicamentos que podem ajudar. Alguns deles tratam os sintomas das doenças. No caso da gripe, por exemplo, eles são utilizados para reduzir sintomas como febre e dores pelo corpo.
Há medicamentos utilizados para matar microrganismos que causam infecções . É o caso dos antibióticos. Até a descoberta do primeiro antibiótico, em 1928, muitas pessoas morriam de doenças que hoje podem ser curadas por esses medicamentos.

LEGENDA: Quando estamos doentes, é importante ficar em repouso, manter uma alimentação saudável e ingerir bastante água para que o corpo possa se recuperar da doença. FIM DA LEGENDA.

LEGENDA: O biólogo Alexander Fleming em seu laboratório, em 1928. Ele descobriu a penicilina, o primeiro antibiótico utilizado como medicamento. FIM DA LEGENDA.
Todos os medicamentos devem ser usados apenas com a indicação e a orientação de um médico. Para que o medicamento contribua para a cura da doença, é preciso seguir as recomendações médicas de dosagem e o período de uso. A automedicação, isto é, tomar remédios sem consultar um médico, pode trazer sérios riscos à saúde.
49

- Leia o balão do quadrinho e responda.

- O cliente da farmácia deve tomar o remédio só porque a amiga dele tomou? Qual seria o procedimento correto?
- Leia o texto, observe a imagem e responda em seu caderno.
Que tal uma reflexão sobre as propagandas de medicamentos e produtos farmacêuticos divulgados pela mídia?
Você liga a televisão, abre um jornal ou revista, vê cartazes e anúncios em outdoors, ônibus, trens, metrô: todos prometem maravilhas e alívios rápidos. [...]
Os medicamentos são essenciais quando receitados e usados adequadamente para diagnosticar, prevenir e curar doenças. Utilizados de maneira incorreta ou consumidos sem orientação médica, podem causar efeitos indesejáveis e oferecer sérios riscos à saúde.
FONTE: ANVISA. O que vale a pena saber sobre a propaganda e o uso de medicamentos. Brasília: Ministério da Saúde, 2008.

LEGENDA: Capa da cartilha da Anvisa sobre o uso de medicamentos. FIM DA LEGENDA.
- Que mensagem a imagem passa para você?
- As propagandas de medicamentos podem oferecer riscos? Explique.
- Faça uma pesquisa em jornais e revistas e selecione propagandas de medicamentos. Observe o espaço que elas ocupam e o que esses medicamentos estão se propondo a curar. Além de benefícios, as propagandas oferecem alguma orientação ou mencionam riscos ou cuidados que o consumidor deve tomar?
50
Equipamentos para diagnóstico
Atualmente, existem muitos equipamentos que permitem a visão de estruturas internas do corpo e que, por isso, ajudam no diagnóstico de doenças. Veja alguns exemplos.
Aparelhos de raios X e tomógrafos possibilitam examinar partes do corpo que não são visíveis externamente. Os raios X são utilizados principalmente para a observação de ossos e cartilagens. Já os tomógrafos possibilitam ver órgãos do corpo, como coração, intestino e cérebro.

LEGENDA: Ossos do antebraço e da mão em uma imagem de raios X. FIM DA LEGENDA.

LEGENDA: Tomografia do abdome de uma pessoa. FIM DA LEGENDA.

LEGENDA: Paciente sendo colocado em um tomógrafo. As imagens produzidas por esse aparelho são utilizadas para auxiliar em diagnósticos. Município de Manaus, Amazonas, em 2020. FIM DA LEGENDA.
51
Os microscópios ópticos permitem analisar diversos materiais, como sangue, urina e fezes. A análise do sangue, por exemplo, permite identificar se as células estão saudáveis e nas quantidades consideradas adequadas. Também é possível saber se há algum microrganismo nocivo à saúde presente no sangue.
LEGENDA: Células do sangue humano saudável vistas ao microscópio óptico, colorizadas artificialmente. Aumento de 630 vezes. FIM DA LEGENDA.
Os exames de fezes também são capazes de identificar a presença de microrganismos causadores de doenças.
- Leia o texto e copie a alternativa correta no caderno.
A malária é causada por um protozoário transmitido pela picada de um mosquito. Dentro do corpo humano, o protozoário vive parte de sua vida no sangue.
- Um método de diagnóstico da malária é:
( ) Exame de raios X, para avaliar a saúde dos ossos do paciente.
( ) Exame de sangue ao microscópio, para verificar se há protozoário no sangue.
( ) Exame de fezes ao microscópio, para verificar se há protozoário nas fezes.
( ) Tomografia, para verificar em qual parte do corpo humano o protozoário se encontra.
- Como a tecnologia pode ser útil nos cuidados com a saúde?

- Você já usou ou costuma usar alguma tecnologia para cuidar da sua saúde? Converse com os colegas sobre as tecnologias que você já usou e o que elas proporcionaram para a sua saúde.
- Um método de diagnóstico da malária é:
52

LEGENDA: Saúde FIM DA LEGENDA.
O mundo que queremos
Calendário de vacinação
Você já deve ter tomado algumas vacinas em sua vida e deve continuar tomando outras ao longo dos anos para proteger sua saúde. A vacinação é um direito de todo cidadão brasileiro.
Desde 2004, existe um calendário obrigatório de vacinação para crianças, adolescentes, adultos e idosos. Isso quer dizer que o governo estabelece regras sobre datas, doses e tipos de vacinas a serem ministrados. Existe até um documento próprio para controlar as vacinas que uma pessoa já tomou e aquelas que ainda deve tomar: é a carteira de vacinação.
Essas ações garantem que muitas doenças sejam erradicadas ou que haja cada vez menos pessoas afetadas por elas.

LEGENDA: Carteira de vacinação. FIM DA LEGENDA.

LEGENDA: Vacinação contra a gripe no município de Londrina, Paraná, em 2020. FIM DA LEGENDA.
Outra ação importante são as campanhas de vacinação. Nas campanhas, o governo divulga informações em vários meios de comunicação e chama a população para ser vacinada.
Um exemplo bem-sucedido foram as campanhas contra a poliomielite, uma doença que causa a paralisia infantil. A vacinação contra essa doença é muito simples, basta engolir três gotinhas. Após as campanhas nacionais de vacinação, essa doença praticamente desapareceu no Brasil.
Mesmo fora dos períodos de campanha, as vacinas podem ser encontradas nos postos de saúde e não têm custo nenhum.
53
Você sabia?
Os animais de estimação também devem ser vacinados. As vacinas, além de protegê-los de doenças específicas de cada animal, também protegem as pessoas de doenças que podem ser transmitidas ao ser humano pelos animais, como a raiva e a leptospirose.

LEGENDA: Campanha de vacinação de cães e gatos do município de Castanhal, Pará, em 2019. FIM DA LEGENDA.
Compreenda a leitura
- Quem tem direito à vacinação no Brasil?
- Quem regula as vacinas, as doses e as datas em que as pessoas
devem
ser vacinadas?

- O que são as campanhas de vacinação?
- Por que os animais também devem ser vacinados?
Vamos fazer

- Observe, abaixo, o cartaz de uma campanha de vacinação contra a
paralisia
infantil.
- Quais informações você obtém nesse cartaz?
- Você já viu algum cartaz parecido? Lembra-se das vezes em que foi vacinado? Converse com os colegas.

LEGENDA: Cartaz de campanha de vacinação contra a paralisia infantil do município de Itararé, São Paulo, em 2018. FIM DA LEGENDA.

- Em grupo, pesquisem quais vacinas
devem
ser tomadas nos dois primeiros anos de vida.
- Escolham uma das vacinas e pesquisem sobre a(s) doença(s) que ela previne.
- Se quiserem, podem pesquisar também sobre as vacinas dos animais de estimação.
- Escolham as informações e elaborem um cartaz. Lembrem-se de que os adultos costumam ler os textos apresentados nos cartazes, mas as crianças pequenas aprendem mais com as imagens!
54
O que você aprendeu
- Leia o texto e observe a imagem.
O musaranho-pigmeu é o menor mamífero (em massa) do mundo. Ele pesa menos que uma moeda de 50 centavos: 2 gramas. Embora pequeno, é possível observá-lo a olho nu.

Comprimento: 5 cm.
- Qual dos instrumentos abaixo você indicaria para as pessoas observarem em detalhes o musaranho-pigmeu? Explique sua resposta no caderno.
( ) Luneta
( ) Lupa
( ) Microscópio
- Qual é a importância desse instrumento?
-
2. Todas as imagens a seguir são de um microrganismo que ataca plantas, causando uma doença chamada ferrugem.
- Que tipo de observação foi feita em cada caso: olho nu (sem instrumento), com lupa ou usando um microscópio? Escreva em seu caderno.



- Em qual das imagens é possível visualizar células?
- A ferrugem é um ser vivo unicelular ou pluricelular?
-
3. As afirmações abaixo estão incorretas. Reescreva-as em seu caderno, fazendo as correções necessárias.
- As células não têm vida.
- Somente organismos pequenos são formados por células.
- As células não precisam de alimento.
55
Avaliação processual
- Observe a tirinha a seguir e depois responda às questões no caderno.

- Por que a menina do segundo quadrinho ficou doente?
- Qual tipo de microrganismo causa a gripe? Cite algumas características desse microrganismo.
- Como a menina do primeiro quadrinho poderia ter evitado a transmissão da gripe para sua colega?
- Cite exemplos de microrganismos que costumam ser usados pelo ser humano em seu benefício.
- Leia o texto e responda no caderno.
As cáries são causadas por bactérias que vivem em nossa boca. Ao se alimentarem dos restos de comida, as bactérias produzem substâncias que corroem os dentes, provocando as cavidades chamadas cáries.
- Como a escovação dos dentes pode prevenir as cáries?
- Observe a fotografia e responda às questões no caderno.

Altura: 10 cm.
- A imagem mostra o fungo inteiro? Explique.
- O que diferencia fungos e plantas?
- Leia o texto e responda à questão no caderno.
Fabíola pegou uma fatia de pão e reparou que ele estava embolorado. Quando mostrou para seu irmão mais velho, ele disse: “Acho que dá pra usar o pão, é só raspar esse bolor”.
- Você concorda com o irmão de Fabíola? Por quê?
- A vacinação é importante? Por quê?